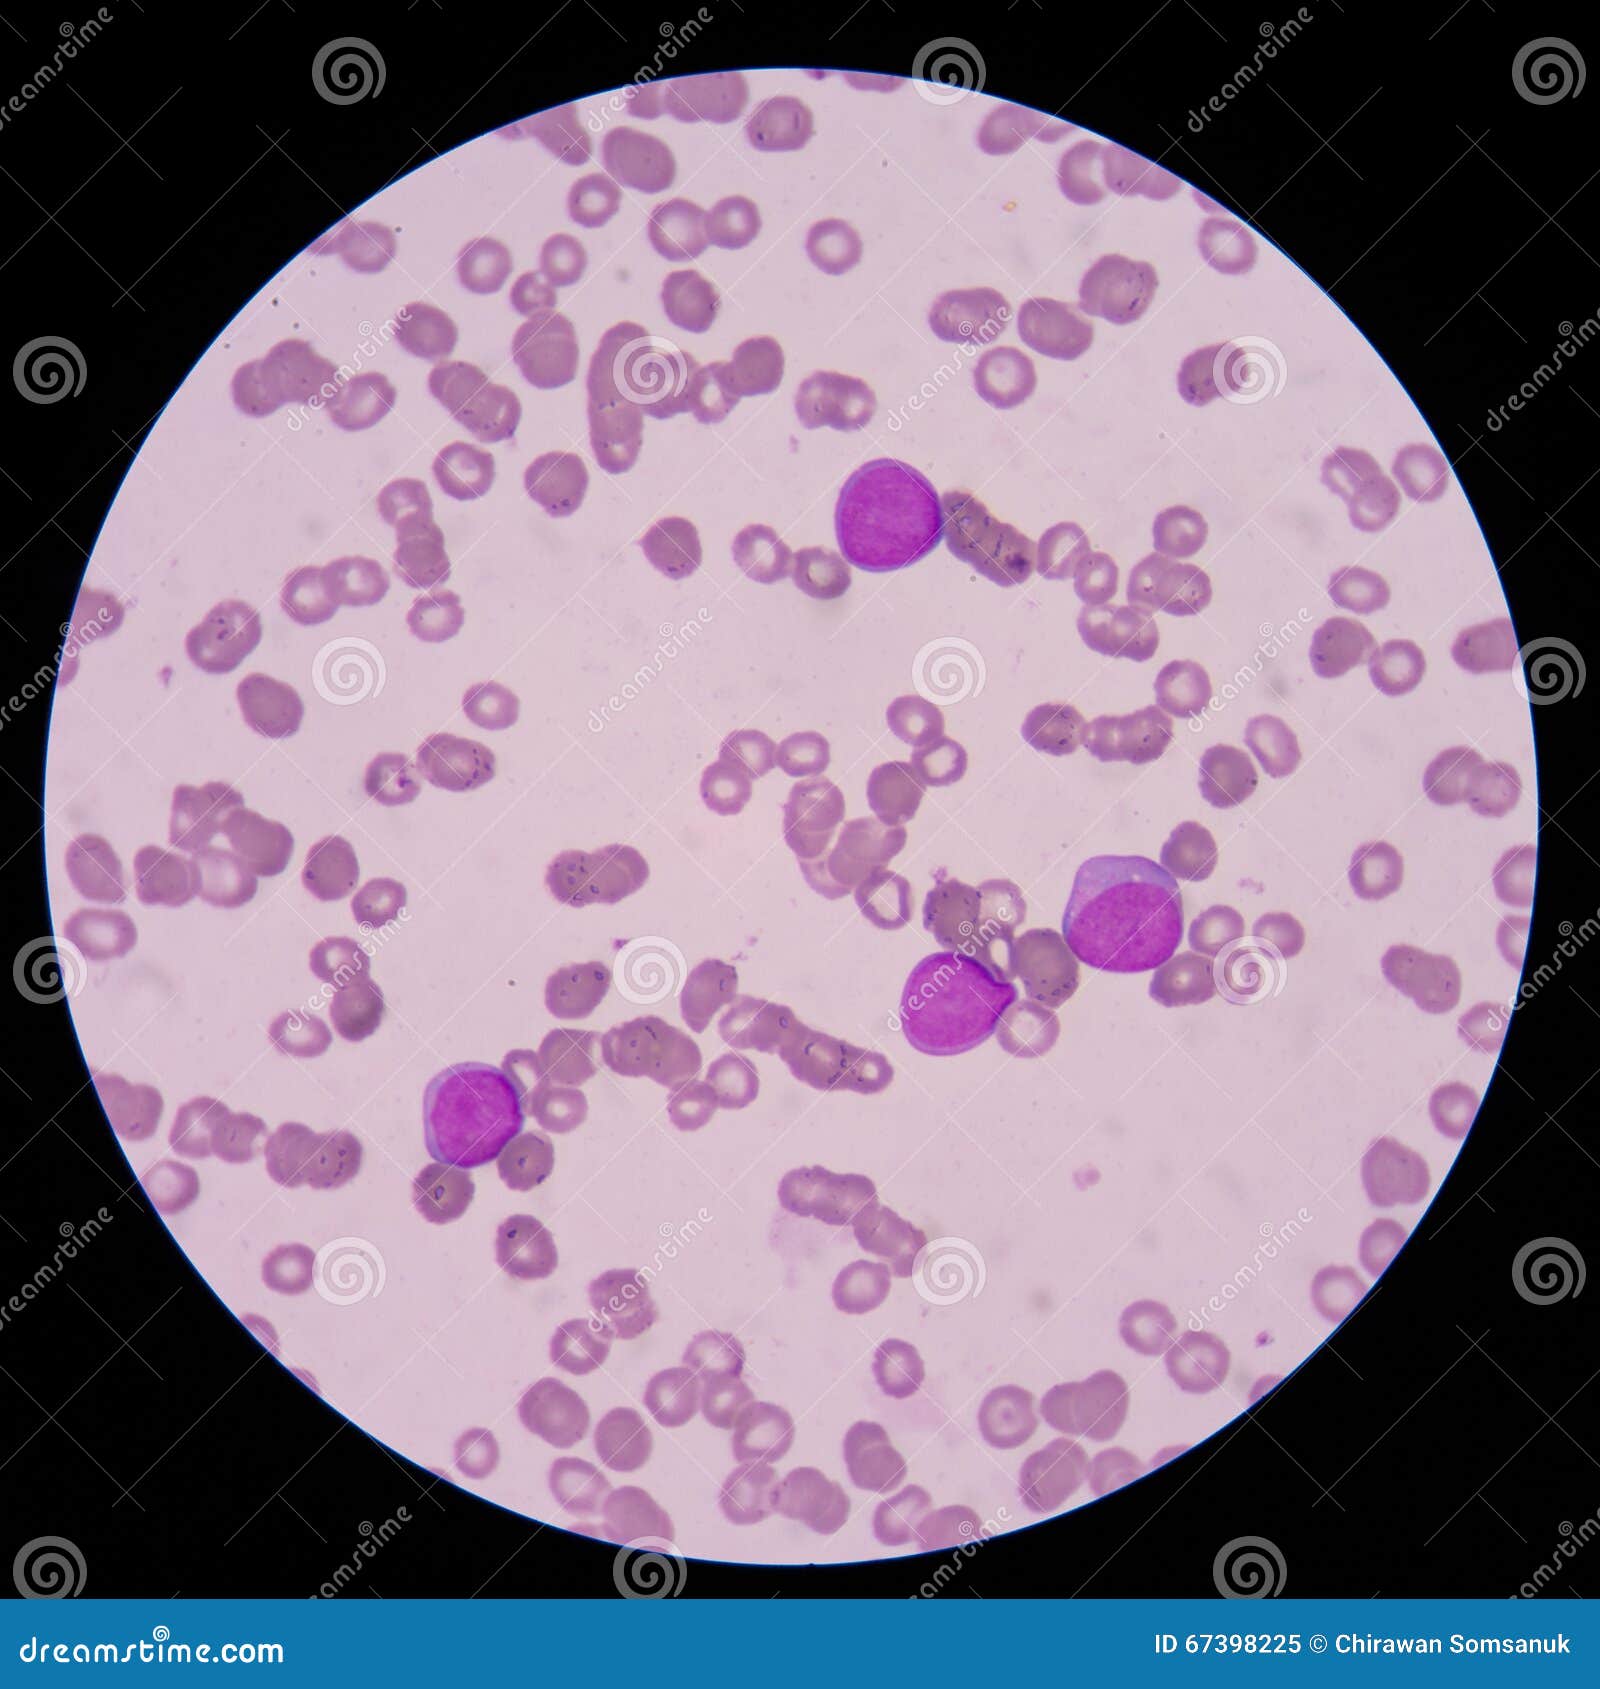

Бласты видео
Шкода фабия реле предохранители
Aw of em перевод
Региональный этап всероссийской олимпиады 2025 2025
Конструктор 3d моделей деревянный
Пивная баня минск
Ария штиль ремикс
Поверхность перуанской пустыни наска покрыта
Качество электрической энергии параметры
Новости на сегодня открытие границы
Песня шур шур плюс
Гари зелимханович
Конкурс фестиваль открытое сердце
Туры на новый год 2025 из перми
Бласты видео 112 фотографий